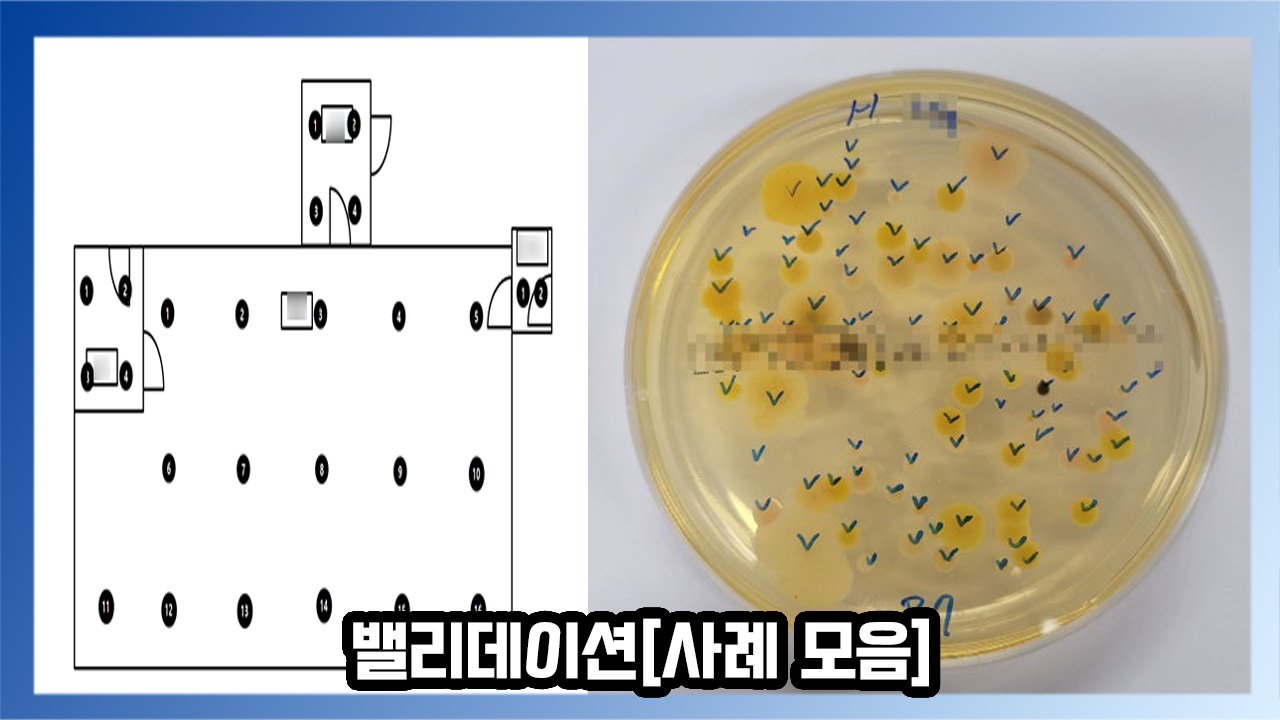
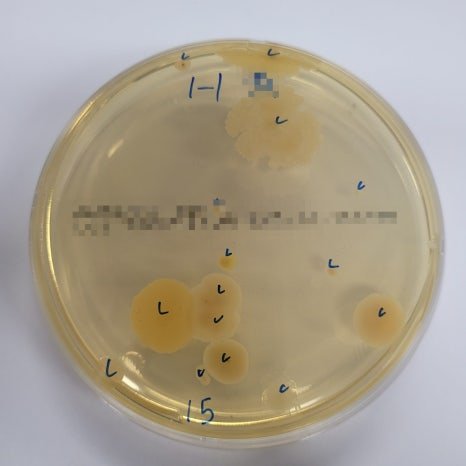
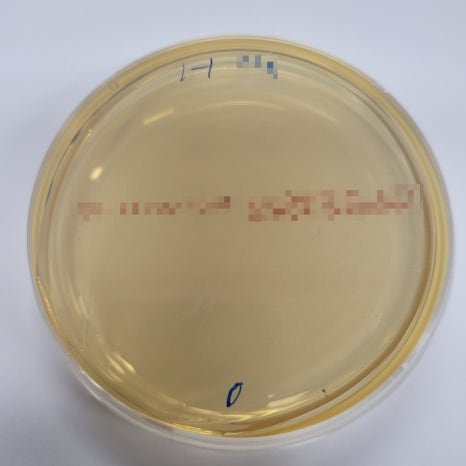
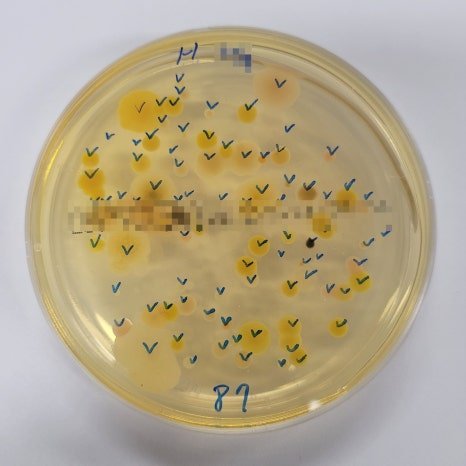
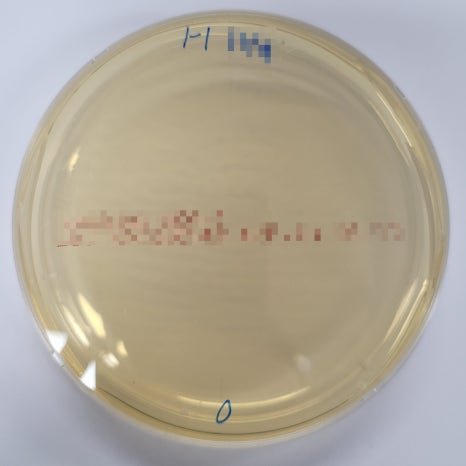
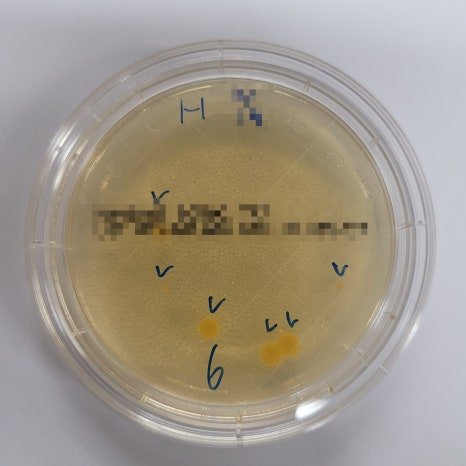
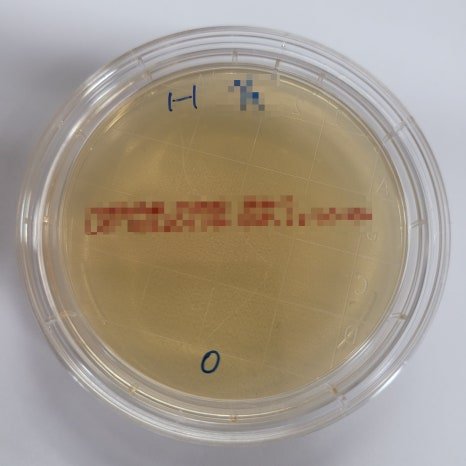

밸리데이션이란
어떤 공정(Process), 설비(Equipment), 방법(Method), 시스템(System)이
미리 정의된 기준에 맞게 일관되게 원하는 결과를 내는지
과학적으로 입증하는 활동을 말합니다
사례 모음
1.경기 용인 의약품 및 의료기기 보관소
창고 밸리데이션 사례로
의약품 및 의료기기 보관소의
온도 분포 검증 사례입니다


보관소에 대하여 실제
작용 조건(적재물 및 보관소 가동 조건)을 대상으로
실시하였으며 위의 사진을 참고하여 온도 데이터 로거를
설치하였습니다
보관소의 공조 시스템 및 온도 제어 시스템을 정상적으로 가동하고,
24시간 동안의 온도 분포를 측정하였습니다
2.경기 청정실
이번 사례는 청정실 밸리데이션 사례로
환경 모니터링을 진행한 사례입니다
조도, 소음도, 온습도, 차압, 부유입자, 낙하균, 부유균, 표면균의 확인들을
진행한 사례입니다

조도, 소음도, 온습도를 측정하기 위해 계측기들을 놓았던
위치들 입니다
1-조도 확인
작업장 바닥을 기준으로 1.5m높이에서 측정을 진행했으며
조도계의 값이 안정화 되었을 때 3회 반복 측정 하였습니다
2-소음도 확인
작업장 바닥을 기준으로 1.5m 높이에서 측정 하였으며
소음계의 감지부는 소음원 방향으로 향하여 소음계의 값이
안정화 되었을 때 3회 반복 측정하였습니다
3-온습도 확인
작업장 바닥을 기준으로 1.5m 높이에 온습도 기록계를
설치하여 1시간 동안 온습도를 측정하였습니다

4-차압 확인
인접한 작업장에서 차압계의 샘플링 튜브를 각각 설치하고
수초 간격으로 3회 반복 측정하였습니다

부유입자, 낙하균, 부유군을 확인하기 위해
계측기를 설치했던 위치입니다
5-부유 입자 확인
청정실 면적에 따른 최소 시료 채취 위치를 설정하고
시료 채취 위치는 청정실에 균일하게 분포되어야하며
실제 작업 위치를 고려하여 선정하였습니다
6-낙하균 확인

낙하균 측정 위치는 부유입자 측정 위치와 동일하게
설정하였으며 선정된 위치에서 채취한 시료를
이용하여 낙하균 측정을 진행하였습니다
7-부유균 확인

측정 위치는 부유입자와 낙하균 측정 위치와
동일하게 선정하였고 Microbial Air Sampler를
이용하여 부유균 포집을 실시하였습니다

8-표면균 확인

표면균의 측정 위치는 청정실을 기준으로 벽과 바닥을 측정하였으며
배지의 전면이 표면에 밀착될 수 있도록 주의하며 각 측정 위치에서
배지의 표면과 접촉시켰습니다
궁금한 사항이나 솔루션이 필요하시다면
필요하신 사양과 어떤 용도로 사용하실지 확인 후
본 페이지 하단의 견적문의란에 남겨주시면 친절하게 안내해 드리겠습니다
언제나 유익한 정보 소개하는 카스스케일 코리아가 되겠습니다















No Comments